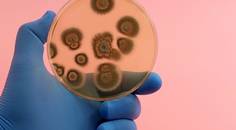
ReachMD Healthcare Image

advertisement
Medical News
Use the tool below to view all available Global Women's Health Academy News Topics
Recent Medical News
medicalxpress.com
01/22/2024
medicalxpress.com
01/22/2024
reuters.com
01/22/2024
today.ucsd.edu
01/19/2024
manchester.ac.uk
01/19/2024
forbes.com
01/18/2024
medicalxpress.com
01/18/2024- Medical NewsStudy Finds No Increase in Preventable Illnesses, Deaths in Kids During Pandemic, But Delays in Some Diagnoses
medicalxpress.com
01/18/2024
health.ucsd.edu
01/18/2024
news.weill.cornell.edu
01/18/2024
medicalxpress.com
01/18/2024- Medical NewsSamsung Electronics Co., Ltd., (Suwon, Republic of Korea) Developed Hip-Assist Robot to Advance Fitness in the Elderly
bioengineer.org
01/18/2024 - Medical NewsRechargeable Deep Brain Stimulation Device Receives Approval from FDA as Treatment for Movement Disorders and Epilepsy
practicalneurology.com
01/17/2024
ualberta.ca
01/17/2024- Medical NewsNonpharmaceutical Interventions Saved Lives and Eased Burdens During COVID’s First Wave, New Study Shows
concordia.ca
01/17/2024 - Medical NewsStudy Examines How Ad Strategies of the Great Depression Can Inform Today's Crisis Communications
news.ku.edu
01/17/2024